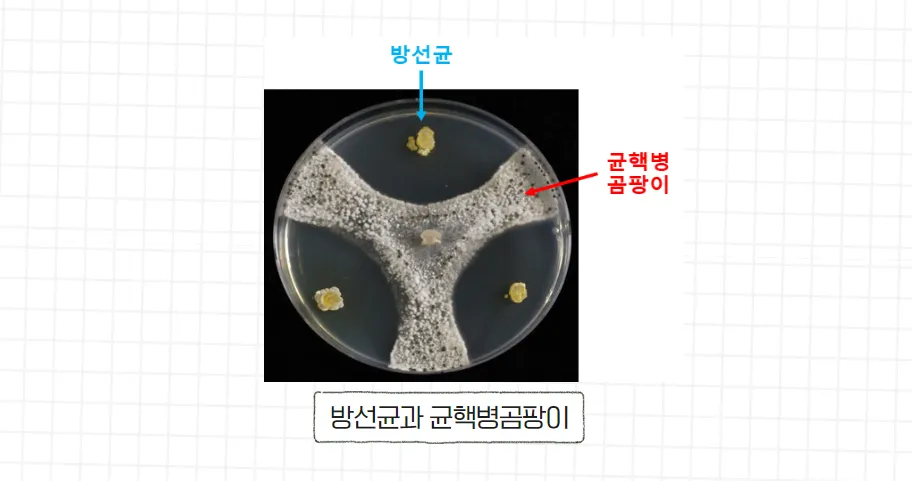
배추 균핵병 막는 자생 방선균 현장 적용 친환경 방제 가능성 확인

국립생물자원관-연구일지
과학이야기
배추 균핵병 막는 자생 방선균 현장 적용 친환경 방제 가능성 확인
2023-12-06
연구일지?
국립생물자원관은 기존 농약 수준의 방제 효능을 갖춘 방선균을
현장에 적용해 친환경 방제 가능성을 확인했다는데요 ?
자생 방선균에 대해서 우리 같이 알아볼까요? ?
균핵병이란?
균핵병이란, 스클레로티니아 속 곰팡이가 원인인데요.
식물체의 조직이나 토양에서 균핵 또는 균사 상태로 월동하다가
이른 봄이 되면 흙에 접촉한 식물의 줄기 부위를 감염시킵니다.
국립생물자원관은 순천대 연구진과 균핵병을
사멸시키는 방선균을 국내 토양에서 찾아 특허를 출원하고
이후 전국 주요 배추 산지에서 현장 적용 연구를 해왔습니다.
자생 방선균의 균핵병 방제효과는?
방선균만 단독 살포 시 기존 농약 대비 약 75~85% 수준으로
균핵병을 억제했고, 방선균과 농약을 3대 1의 비율로 혼합처리 시
농약과 같은 수준(95% 이상)의 효과를 보였습니다.
또한 배추의 무게가 약 1.2배 증가하는 등 생장 촉진 효과도
보였으며 대표적인 쌈채소인 상추, 청경채 등에서
발생하는 균핵병도 비슷한 효능이 나타났습니다.
*방선균 : 토양에 주로 서식하며 유기물을 분해해 흙냄새를 유발하는 미생물
친환경 미생물 소재 개발의 미래
연구진은 방선균을 대량증식해 화학 농약을 대체할 수 있도록
보리를 활용한 고체 배양법을 개발하고 관련 기술을
기업에 이전할 계획입니다.
이번 연구는, 자생생물의 유용한 효능이 실제로 증명된 사례이며,
국립생물자원관은 우리나라 미생물자원이 산업적으로
활용될 수 있도록 더욱 노력하겠습니다.
▼ 국립생물자원관의 자생생물 연구생활?이 더 궁금하다면?▼
- 다음
- 울릉도 인근 바다, 열대·아열대성 어류가 절반 이상을 차지 2023.12.20
- 이전
- [연구일지] 태평양 섬나라 마이크로네시아 연방코스라에주에 생물표본실 설치 2023.11.24